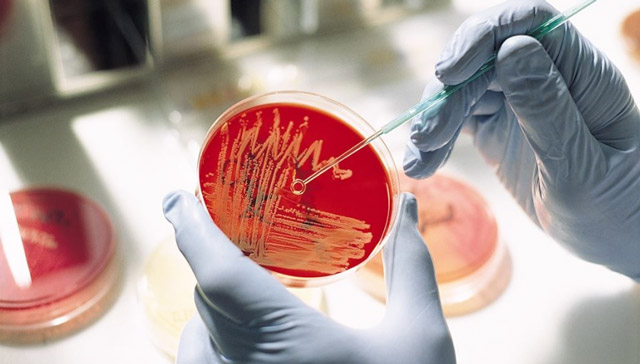

У грудничка при дисбактериозе кишечника часто доминируют клостридии. Как интерпретировать подобные результаты анализа? Нужно ли немедля обращаться к бактериофагам для снижения уровня популяции, либо клостридии неопасны? В российской медицине чаще применяется бактериологическое исследование: проба высевается на питательную среду, потом ожидается результат. Бакпосев кала занимает неделю. Клостридии в анализе на дисбактериоз означают необходимость пенициллина для лечения.
Бактерии, вызывающие отравления, не слишком опасны. Однако приготовьтесь к продолжительной диарее. Указанный вид убивается антибиотиками. Врач может назначить таблетки наугад, но лучше подождать результаты анализов, занимающих неделю, если в клинике не применяются экспресс-методики с выявлением метаболитов нужных штаммов в каловых массах. Заболевания, связанные с ЖКТ, дискомфортны, мешают вести привычный образ жизни.
Из истории
Род клостридий при проникновении в человеческий организм становится причиной ряда заболеваний. Часть полного списка:
Вырабатываемый некоторыми штаммами яд настолько силен, что считается опаснейшим в природе. Речь идёт о возбудителях ботулизма. В случае обнаружения клостридий через бакпосев, не стоит ожидать смертельных последствий, хотя признаки пищевого отравления будут налицо.
Сведения, полученные из истории, заставляют задуматься. Ряд областей Германии, где любят колбасы, пострадал от ботулизма. Череда вспышек болезни приходится на конец XVIII века. Неудивительно, что немецкие учёные всерьёз заинтересовались патологией. В 1817 году Юстинус Кернер обнаружил палочковидные бактерии в заражённых продуктах.
В 1897 году появилась первая научная работа за авторством Эмиля ван Эрмингема об эндоспоровом организме, локализованном из ветчины. Биологи классифицировали находку как грамположительную бактерию. Сюрпризом явилось знание, что бациллы росли исключительно в отсутствии кислорода, считавшимся необъяснимым. Название клостридии появилось в 1924 году, когда Ида Бенгстон показал, что микроорганизмы – бактерии нового вида.
Сюда немедля причислили сонм разновидностей, не все клостридии являются возбудителями страшных заболеваний. Данный вид патогенных организмов вызывает отравление, считается вероятной причиной простатита.
Анализы
В клиниках РФ анализ на клостридии возможен. Предметом исследования становится кал. В перечнях идёт под номером А26.19.007. Для краткости медики называют анализ посевом на клостридии.
Показания
Особенно важно правильно собрать анамнез у детей, младенец не сможет высказать жалобы. Анализируйте испражнение для постановки выводов. Клинические признаки отравления клостридиями:
- Стул жидкий с зелёным оттенком, сильным запахом гнили. Порой присутствует кровь либо слизь.
- В животе режущая боль. Симптом сложно определяется у грудных младенцев.
Как собирать
Подготовка к сдаче включает подготовку, занимающую много времени.
- За 1 неделю до приёма у врача исключите из рациона антибиотики, слабительное. Не вставляйте в задний проход свечи.
- За несколько дней до сдачи анализа уберите из диеты острые, кислые, жирные блюда. Нежелательным является употребление свёклы, недопустимым – алкоголя. Ешьте поменьше рыбы, мяса.
- К сдаче кала подберите чистую, плотно закручивающуюся банку. Либо купите контейнер в клинике.
Перед сдачей стоит вымыть задний проход. Материал сдается в течение двух часов. По истечении указанного времени сдача образца не имеет смысла. Просчитайте заранее, сколько придётся стоять в очереди. У взрослого не вызовет затруднений сделать необходимые мероприятия в уборной поликлиники.
Клостридии умирают в воздушной среде, поплотнее закрывайте крышку.
Процесс исследования
Набранный материал высевается на питательные среды, где анализируется рост нужной культуры. Позже штамм проверяется на чувствительность к антибиотикам. Подобным действием обеспечивается точечный удар в нужном направлении.
Сколько стоит?
Анализ является редким и сложным, приготовьтесь выложить сумму от 400 до 1000 рублей. Цена зависит от места проведения исследования. Для Москвы и государственной поликлиники средняя цена составляет 200 рублей.
Некоторые клиники, к примеру, Хеликс, не делают индивидуальных посевов на клостридии, придётся заплатить дороже.
Что означает положительный результат
Расшифровка анализа на дисбактериоз ложится на плечи врача. Присутствие возбудителей ботулизма либо столбняка ведет к гибели реципиента, в анализах показатели отсутствуют. Дисбактериоз кишечника с определением чувствительности указывает на присутствие гораздо менее опасных, неприятных штаммов.
В первую очередь, речь о Clostridium perfringens, провоцирующих признаки пищевого отравления. Острое состояние вызывает наличие Clostridium difficile. Заболевание протекает по-разному у взрослых и детей, начиная полным отсутствием симптомов, заканчивая сильнейшим колитом.
Типичные цифры плотности популяции выглядят подобным образом:
- Дети до года – 1 тыс. ед. на г.
- У взрослого – 100 тыс. ед. на г.
- Пенсионный возраст – 1 млн. ед. на г.
Приведённый список служит эскулапам точкой отсчета, примерной сводной таблицей. Окончательная расшифровка остаётся за врачом. Исследование может пойти по ложному пути, если в образцы случайным образом попала кровь. Чтобы правильно поставить диагноз, придётся выполнить дополнительные мероприятия.
Порой посев не является действенным методом. Обследование образцов проводится на выделяемые клостридиями токсины, сила которых уже описана. Делают анализ по отличающейся технологии. Ответ получается быстрее, отсутствует надобность ожидать рост штамма.
Лечение
Традиционно клостридии лечат пенициллином. Множество штаммов уязвимо при лечении дисбактериозов антибиотиками:
- Тетрациклин.
- Метронидазол.
- Сульфаниламид (стрептоцид).
При варке бактерии погибают при температуре 75 градусов Цельсия, споры – 120 градусов. Мораль проста: употребляйте варёную пищу, хорошо приготовленную. Одновременно составляется лечебная диета. Считается, что клостридии угнетаются культурами, питательной средой которым служит инулин. Больной (по возможности) должен получать продукты из приведённого перечня:
Старайтесь включить в пищу фруктоолигосахариды. Регулярно потребляйте крупы, кукурузу, обычный хлеб (грубого помола), стимулируя рост бифидобактерий, мешающих клостридиям размножиться.
У меня нет клостридий
Большая часть анализов на дисбактериоз концентрируется вокруг заднего прохода. От бактерий страдает и мочеполовая система, симптомы отличаются. Простатит в отдельных случаях вызван бактериями, появление микроорганизмов в мочеиспускательном канале указывает на третью стадию дисбактериоза. Задумайтесь об этом.
С желудка и кишечника начинаются неприятные болезни. Многие учёные в работах заявляют, что в указанных органах стартует рак. На первый взгляд, связь отсутствует, но учёные говорят о сумасшедшем проценте корреляции – свыше 99. Недаром рак уже окрестили болезнью печали. И дисбактериоз, как выяснено, развивается из-за стресса. Лишний повод задуматься!
Клостридии – распространенная разновидность микроорганизмов, которые способны в виде спор сохранять жизнеспособность в условиях отсутствия воздуха. Клостридии в кале у взрослого человека могут быть вариантом нормы. Однако при существенном повышении уровня бактерий стоит провести детальное обследование. Иногда это является признаком серьезных патологий.
Почему нужно опасаться клостридий?
Clostridium perfringens и Clostridium difficile – это анаэробные бактерии, которые встречаются довольно часто. Они могут присутствовать на поверхности дермы и слизистых покровов. Также микроорганизмы нередко выявляются в половых путях.
При существенном увеличении количества бактерий есть риск развития таких нарушений:
Клостридии представляют опасность исключительно при существенном превышении нормы. Это провоцирует нарушение здоровой микрофлоры. В результате меняется соотношение лакто- и бифидобактерий и условно-патогенной флоры.
При ослаблении иммунной системы клостридии начинают продуцировать ферментные вещества, которые приводят к расщеплению белков. Как следствие, в кишечнике человека начинаются процессы брожения и гниения. Это провоцирует ухудшение процесса пищеварения.
При выявлении в кале взрослых людей Clostridium botulinum, который представляет собой возбудителя ботулизма, можно не переживать. Это микроб представляет опасность лишь для детей раннего возраста. В организме взрослого человека бактерия не способна продуцировать экзотоксин и провоцировать появление болезни.
Пути заражения
Клостридии живут на поверхности дермы и в окружающей среде. Потому предотвратить процесс заражения довольно сложно. В человеческом организме находится довольно много различных микробов, однако состояние здоровья напрямую зависит от их количества.
Потому врачи не советуют стараться полностью избавиться от каких-либо бактерий, включая клостридии. Это может спровоцировать всевозможные нарушения в работе организма.
При этом заражение микроорганизмами осуществляется такими способами:
- контактно-бытовой – инфицирование происходит при контакте с больным человеком или использовании общих бытовых предметов;
- алиментарный – вследствие потребления инфицированных продуктов;
- водный – в результате потребления воды с микроорганизмами.
Clostridium difficile и perfringens все время присутствуют в организме. Потому клостридии в кале не являются основанием для тревоги. В данном случае имеет значение не факт выявления бактерий, а их количество.
Причины повышения уровня микроорганизмов
Рост числа клостридий в кале наблюдается вследствие различных факторов. К наиболее распространенным причинам стоит отнести следующее:
- прием антибиотиков;
- неблагоприятные экологические условия;
- стрессы;
- ослабление иммунитета;
- нарушения режима дня, бессонница;
- мозговая гипоксия;
- несбалансированный рацион;
- простудные и вирусные болезни;
- кишечные инфекции;
- оперативные вмешательства;
- применение гормональных препаратов и иммунодепрессантов.
Показатели нормы
Нормы клостридий в каловых массах зависят от возрастной категории:
- до 60 лет – менее 105 КОЕ/г;
- после 60 лет – до 106 КОЕ/г.
Под КОЕ понимают колониеобразующие единицы. Если анализ кала на клостридии показывает превышение нормы, рекомендуется проконсультироваться с врачом.
Важно учитывать, что Clostridium difficile продуцируют разные токсины. Это вызывает неприятные симптомы – от небольшой диареи до сложных поражений пищеварительной системы.
К основным веществам относят токсины А и В. Тип А представляет собой энтеротоксин, который воздействует на цитоскелет эпителиальных клеток и провоцирует нарушение их функций. Токсин типа В обладает цитопатологическим эффектом.
Именно анализ кала на токсины А и В клостридий считается наиболее информативным методом исследования. Он является более точным, в отличие от посева кишечного содержимого.
Исследование кала на токсины клостридий А и Б позволяет выявить токсикогенный штамм и определить причины появления диареи. При этом посев дает информацию лишь о наличии патогенных бактерий. При этом он не позволяет оценить способность вырабатывать токсины.
Клиническая картина
Клостридиоз не имеет характерных симптомов. Клиническая картина зависит от зоны локализации инфекционного процесса. Но существует несколько признаков, которые присутствуют всегда.
Итак, к ключевым симптомам клостридий в кале у взрослого стоит отнести следующее:
- метеоризм;
- диарея;
- увеличение температурных показателей до 39 градусов;
- резкие боли и спазмы в животе;
- уменьшение веса при нарушении самочувствия и потере аппетита;
- тошнота и рвота;
- кровянистые примеси в рвотных массах;
- усиление болевого синдрома при пальпации живота;
- жидкий стул с наличием крови и непереваренной пищи.
Если споры микроорганизмов спровоцировали столбняк, есть риск появления таких признаков:
- тупые боли тянущего характера;
- напряжение жевательных мышц;
- судорожный синдром;
- резкая приступообразная боль;
- нарушение глотательных функций.
Многие люди интересуются, почему необходимо немедленно обращаться к специалисту при появлении подозрительных симптомов. В сложных случаях резкое увеличение числа клостридий в организме может привести к смерти больного.
Диагностические мероприятия
Чтобы выявить наличие условно-патогенных бактерий в организме, рекомендуется провести целый ряд диагностических процедур. В большинстве случаев бывает достаточно лабораторных анализов. При потребности проводятся инструментальные процедуры.
Обязательным методом диагностики считается анализ кала на клостридии А и Б. Чтобы выявить клостридиоз, нужно провести такие процедуры:
- Физикальный осмотр. Врач выполняет сбор анамнеза, изучает симптомы, анализирует питание пациента.
- Общие анализы крови и кала.
- Биохимическое исследование.
- Иммунологический анализ.
- Исследование кала на клостридии.
Если лабораторные исследования не помогли выявить причины появления неприятных симптомов, рекомендуется провести инструментальные процедуры. Чаще всего врачи назначают ультразвуковое исследование органов брюшной полости и мочеполовой системы.
Сбор кала
Чтобы диагностика была информативной, важно правильно собрать материал для исследования. При этом стоит учитывать такие особенности:
- В случае применения антибактериальных препаратов сдавать анализ рекомендуется не раньше, чем через 2 недели после завершения лечения.
- За 3 дня до проведения обследования рекомендуется исключить применение слабительных препаратов, средств от диареи и глистов. Также не рекомендуется применять нестероидные противовоспалительные препараты, пробиотики, касторку, вазелиновое масло, препараты с содержанием висмута и бария.
- Собирать материал стоит в стерильный пластиковый контейнер с ложечкой и крышкой. Эта емкость должна быть предназначена для сбора и транспортировки каловых масс.
- Опорожнение кишечника должно быть естественным. При этом не рекомендуется применять клизму или другие средства.
- Перед началом дефекации обязательно стоит опорожнить мочевой пузырь, после чего помыться и вытереться. При наличии менструации у женщин рекомендуется использовать тампон.
- После завершения процесса дефекации нужно открыть контейнер и с помощью специальной ложки собрать небольшое количество кала из разных частей – с поверхности и из середины. При наличии подозрительных участков их обязательно следует поместить в контейнер. В общей сложности потребуется 6-8 ложек материала.
Запрещено собирать образец из унитаза. Для этого рекомендуется подготовить удобную емкость, тщательно помыть ее, обдать кипятком и просушить.
https://youtube.com/watch?v=c55qvAWEGww
Условия хранения
Чтобы анализ был информативным, нужно обеспечить материалу правильное хранение. Для этого контейнер необходимо плотно закрыть и доставить образец в лабораторию. Это необходимо сделать не позже, чем через 2 часа после сбора кала.
Лечебный процесс
Если объем клостридий не превышает норму, никаких специальных мероприятий не требуется. Лечение назначают при существенном повышении числа микроорганизмов, что спровоцировало нарушение функций органов пищеварения и общего состояния. Терапия включает прием лекарственных средств, соблюдение диеты и нормализацию образа жизни.
Диета
При выявлении клостридиоза обязательно рекомендуется соблюдать особую диету. Для этого из рациона стоит исключить следующее:
- продукты, которые обладают послабляющим эффектом, – к ним относят чернослив, свеклу, бобовые;
- консервы;
- маринады, жирные, жареные, острые продукты;
- фастфуд;
- грибы;
- овощи, которые содержат много эфирных масел, – лук, редис, чеснок;
- колбасные изделия;
- газированная вода;
- алкогольные напитки;
- сладкие продукты.
В меню должны присутствовать продукты, которые оказывают скрепляющий эффект. К ним относят рис, бананы, печеный картофель. Также полезно пить отвар изюма. Помимо этого, необходимо есть продукты с содержанием молочнокислых бактерий – йогурт и кефир.
Пищу рекомендуется употреблять маленькими порциями, чтобы уменьшить нагрузку на органы пищеварения. Во время диареи все продукты следует варить и протирать. Еда не должна быть чересчур холодной или горячей.
В меню стоит включить такие продукты:
- печеные и вареные овощи;
- некислые фрукты и ягоды;
- зелень;
- нежирное мясо и рыба;
- злаки;
- зеленый чай;
- растительные масла;
- яйца;
- кисломолочные продукты;
- отвар шиповника.
Гигиенические процедуры
Чтобы избежать опасных последствий для здоровья, при клостридиозе стоит особое внимание уделить гигиене. Для этого необходимо соблюдать такие рекомендации:
- постоянно мыть руки с мылом;
- использовать индивидуальную посуду;
- минимизировать контакты с окружающими, чтобы избежать их заражения.
Медикаментозные препараты
При выявлении чрезмерного количества клостридий в организме стоит принимать меры для нейтрализации синтеза токсических веществ и нормализации микрофлоры кишечника. Чтобы справиться с бактериями, применяют антибактериальные препараты, которые способны подавить их активность. Для этого применяются следующие средства:
Лечение клостридиоза зависит от того, какие органы и системы пострадали:
- При развитии газовой гангрены необходимо применять оперативное вмешательство. Оно направлено на иссечение пораженных тканей. После этого назначается антибактериальная терапия раны.
- При наличии ботулизма или столбняка нужно нейтрализовать токсины. Для этого используют иммуноглобулин и специальную сыворотку.
- К симптоматическим средствам относят гепатопротекторы, пробиотики, противовоспалительные средства, уросептические препараты. Для этого применяют «Креон», «Энтерол», «Бактериофаг». Данные средства направлены на заселение кишечной микрофлоры полезными микроорганизмами. Благодаря этому удается существенно уменьшить число клостридий. Такие задачи успешно решают «Линекс», «Лактобактерин», «Хилак-Форте».
Профилактика
Чтобы предотвратить появление проблем, нужно соблюдать такие рекомендации:
- употреблять исключительно свежие продукты высокого качества;
- поддерживать гигиену;
- систематически делать влажную уборку;
- контролировать здоровье домашних питомцев.
Наличие клостридий в кале далеко не всегда свидетельствует о развитии опасных патологий. При этом существенное повышение числа этих микроорганизмов становится причиной серьезных последствий для здоровья. Потому при появлении подозрительных симптомов нужно сразу обращаться к врачу.
Клостридии (clostridium) — нормальные обитатели микрофлоры человека, способные при определенных условиях интенсивно размножаться, приобретать патогенные свойства и вызывать развитие заболеваний. Они относятся к облигатным анаэробам, живущим в отсутствии кислорода или при крайне низком его содержании. Клостридии выполняют ряд важнейших функций в организме: расщепляют белки, тонизируют кишечную стенку и стимулируют перистальтику.
Термин «клостридии» в переводе с древнегреческого языка означает «веретено». Это связано со способностью микробов раздуваться в центральной части при спорообразовании и приобретать соответствующую форму.
Клостридии являются обитателями микрофлоры кишечника, женской половой сферы, кожного покрова, респираторного тракта и полости рта. Количество клостридий в кале здоровых людей может колебаться, что необходимо учитывать в процесса диагностики. У лиц старше 60 лет количество клостридий в фекалиях составляет 10 6 КОЕ/г, у детей старше года и у взрослых – до 10 5 КОЕ/г. Клостридии в кале у ребенка первого года жизни не должны превышать 10 3 – 10 4 КОЕ/г.
По механизму возникновения все клостридиозы классифицируют на:
Clostridia под микроскопом
Клостридии окрашиваются по Грамму в синий цвет и имеют палочковидную форму, в мазке располагаются попарно или короткими цепочками. Они подвижны и размножаются при полном отсутствии кислорода.
Благодаря способности образовывать споры микробы устойчивы к нагреванию, воздействию антибиотиков и современных дезинфектантов. Центрально расположенная спора придает бактериям форму веретена, а терминально расположенная — форму барабанных палочек.
Клостридии вырабатывают токсины и вызывают развитие клостридиозов, к которым относятся: ботулизм, столбняк, газовая гангрена, клостридиальная пищевая инфекция.
- Токсигенность. Клостридии вырабатывают мощные микробиологические токсины – ботулотоксин, тетаноспазмин, токсин, разрушающий эритроциты. Благодаря способности к токсинообразованию бактерии оказывают нейротоксическое, гемотоксическое, лейкотоксическое, некротоксическое и летальное воздействие на организм. Для патогенных клостридий характерен летальный и нелетальный паразитизм.
- Инвазивность, обусловленная ферментативной активностью бактерии.
- Выработка гидролитических ферментов — протеиназы, коллагеназы, лецитиназы и гиалуронидазы, желатиназы, ДНК-азы, нейраминидазы.
- Перитрихиально расположенные жгутики, обеспечивающие подвижность и адгезию.
- Штаммы некоторых клостридий синтезируют энтеротоксин, действие которого аналогично токсинам энтеротоксигенных эшерихий, оказывающим повреждение кишечной стенки.
Клостридии растут в глубине среды Вильсон-Блер. Колонии имеют шаровидную или чечевидную форму черного цвета. Бактерии обладают слабой биологической активностью: не восстанавливают сульфаты в сульфиды, не синтезируют каталазу и цитохромы, не содержат флавиновых ферментов.
Клостридиоз — заболевание, характеризующееся выраженными некротическими и общетоксическими изменениями, которые являются основными и преобладают над воспалительными процессами. Это основной отличительный признак анаэробной инфекции от аэробной. Некроз, отек и газообразование в тканях — патоморфологические признаки любых клостридиозов.
Эпидемиология
Сульфитредуцирующие клостридии с фекалиями больного человека или бактерионосителя попадают во внешнюю среду и довольно долго сохраняют свою биологическую активность в почве. Для клостридиозов характерна осенне-летняя сезонность, спорадическая и вспышечная заболеваемость. Восприимчивы к клостридиозам представители различных возрастных группах, но в наибольшей степени — дети.
Механизмы распространения инфекции – фекально-оральный и контактно-бытовой, которые реализуются пищевым и контактным путями.
- Инфекция передается алиментарным путем через пищевые продукты – мясо, фрукты и овощи, молоко. Для ботулизма это продукты с малым содержанием кислорода – консервы, соленья, копченая, вяленая рыба и колбаса, приготовленные дома.
- Контактный путь — передача возбудителя через инфицированные предметы окружающей среды и грязные руки.
Под воздействием токсинов в тонком кишечнике нарушается транспорт глюкозы, поражается эпителий, слизистая становится гиперемированной, отечной, на ней появляются геморрагии, язвы и очаги некроза. Токсины оказывают капилляротоксическое действие, что приводит к дистрофическим и некробиотическим процессам во внутренних органах.
Активация собственной микрофлоры человека может стать причиной клостридиоза. После лечения антибиотиками или цитостатиками размножение клостридий усиливается.
Факторы, способствующие развитию клостридиозной инфекции:
- Напряженная экологическая обстановка,
- Стрессы,
- Длительная гормональная и антибактериальная терапия,
- Иммунодефицит,
- Недоношенность,
- Дисфункции ЦНС,
- Хроническая бессонница,
- Внутрибольничные инфекции,
- Респираторные инфекции,
- Операции.
Формы и симптоматика
Ботулизм — опасная инфекция, развивающееся в результате воздействия на человеческий организм ботулотоксина – продукта жизнедеятельности бактерии Clostridium botulinum. Первыми клиническими признаками патологии являются: сильные боли в эпигастрии, приступообразная головная боль, жидкий стул, многократная рвота, общее недомогание, лихорадка. Внезапно нарушается зрение, появляется двоение в глазах, теряется четкость предметов, перед глазами плавают мушки. Ботулизм проявляется афонией, дисфагией, офтальмоплегией, параличами и парезами глоточных и гортанных мышц. Больные поперхиваются жидкой пищей, у них нарушается фонация и артикуляция, голос становится «носовым», гнусавым, осиплым. Разгар болезни проявляется шаткостью походки, мышечной гипотонией, дизурией, бледностью кожи, тахикардией. В заключительной стадии заболевания преобладают симптомы нарушения дыхательной функции: одышка, чувство сжатия или стеснения в груди, удушье.

Газовая гангрена – специфическое поражение глубоко расположенных раневых поверхностей, вызываемое Clostridium perfringens (клостридия перфрингенс). Через пару дней после получения тяжелой травмы появляются симптомы патологии. В ране создаются необходимые условия для роста и развития клостридий: отсутствует кислород, имеются омертвевшие клетки. Бактерии в очаге продуцируют токсины, что приводит к тяжелой интоксикации организма. Пораженные ткани отекают и отмирают. Симптомами патологии являются: крепитация, возникающая при пальпации пораженной ткани; зловонное отделяемое из раны; лихорадочное состояние.
Псевдомембранозный колит является следствием антибиотикотерапии. У больного развивается дисбактериоз кишечника с преобладающей активностью Clostridium difficile (клостридия диффициле). Микроб колонизирует слизистую кишечника и выделяет энтеротоксин и цитотоксин. Воспаление слизистой сопровождается образованием «псевдомембран», которые представляют собой фибринозные налеты. При отсутствии активной терапии колита развиваются тяжелые осложнения – прободение кишечной стенки, перитонит и летальный исход. Обычно данное заболевание возникает у лиц преклонного возраста, онкологических больных, пациентов после операций. Патология имеет острое начало. У больных появляется лихорадка, метеоризм, схваткообразные болезненные ощущения в животе, упорная рвота, отрыжка, головная боль и прочие симптомы интоксикации. У них развивается анорексия, кахексия, неухоженность, потеря телесного веса, тенезмы, потуги, моральная подавленность, депрессия. Резко снижается иммунитет, возникает диарея. Жидкий стул содержит наложения фибрина и издает гнилостный запах.
Некротический энтерит — воспаление стенки кишечника с образованием очагов некроза, эррозий и язв. У больных поднимается температура, озноб, диспепсия, жидкий стул с кровавой пеной. Специалисты обнаруживают гепатоспленомегалию, резкое вздутие живота, указывающее на парез кишечника. Возможно развитие кровотечений, тромбоза артериол и венул, прободения язв. Некротический энтерит обычно развивается у ослабленных лиц, детей и пожилых людей.
Пищевая токсикоинфекция, вызванная клостридиями, проявляется классическими симптомами пищевого отравления: лихорадкой, диареей, диспепсией, отсутствием аппетита, болью в животе. Диспепсический и интоксикационный синдромы — основа данной формы патологии. Больные становятся вялыми и беспокойными. Симптомы сохраняют 3-4 дня, а потом утихают.
Диагностика
Диагностика клостридиозов начинается с изучения симптомов заболевания, выяснения его взаимосвязи с травмой, антибактериальной терапией, употреблением определенных продуктов. Диагноз ставится с учетом анамнеза, эпидемиологических факторов, клинических проявлений. Лабораторные и инструментальные методики позволяют поставить окончательный диагноз.
- Микроскопическое исследование биоматериала позволяет обнаружить грамположительные палочки со слегка закругленными концами и спорами.
- Бактериологическое исследование. Материал для исследования — раневое отделяемое, испражнения, рвотные массы, моча, кровь, трупный материал. Подготовка для сдачи анализа не требуется. В микробиологической лаборатории биоматериал засевают на специальные питательные среды — Кита-Тароцци или Вильсон-Блер. Посевы инкубируют в анаэростате 3 суток. На Вильсон-Блер появляются черные колонии, растущие в глубине среды и имеющие шаровидную и чечевицеобразную форму. Подсчитывают их общее количество, подтверждают принадлежность к клостридиям изучением мазка по Грамму. Затем проводят полную идентификацию выделенного возбудителя до вида. Посев кала для определения рода и вида возбудителя проводят в бактериологической лаборатории.
- Биологическая проба на белых мышах проводится с целью выявления токсинов клостридий и их нейтрализации.
- Антигенный тест выполняют в иммунологических лабораториях ЛПУ и диагностических центров.
- Экспресс-диагностика – исследование кала методом иммуноферментного анализа, позволяющее обнаружить в фекалиях больного энтеротоксин.
- Биопсия слизистой оболочки кишечника выявляет характерные воспалительные изменения.
- Серодиагностика – определение токсина в РНГА с антительным диагностикумом и постановка реакции встречного иммуноэлектрофореза.
- Инструментальная диагностика – рентгенография кишечника, в ходе которой специалисты-рентгенологи обнаруживают скопление газа в тканях организма.
- Эндоскопическое и томографическое исследование дает картину локального или разлитого воспаления кишечника с наличием псевдомембран.
Если в бактериологическом анализе кала у грудного ребенка повышены клостридии, это указывает на имеющий дисбактериоз кишечника. При этом у грудничка появляется вздутие живота, частые срыгивания, снижение аппетита, нерегулярный стул, нарушение сна. Количество бактерий в кале у грудных детей, превышающее 10 4 — признак патологии, которую необходимо лечить.
Нормальное содержание клостридий в анализе на дисбактериоз обеспечивает оптимальную работу желудочно-кишечного тракта. Если их количество резко увеличивается, появляется диарея, вздутие и прочие признаки диспепсии.
Лечение
Клостридиозы — заболевания, требующие лечения в условиях стационара и оказания квалифицированной медицинской помощи. Если у больного имеются диспепсические симптомы и интоксикация, ему промывают желудок и ставят очистительную клизму. В течение первых суток специалисты рекомендуют соблюдать водно-голодную диету.
Антитоксические сыворотки и иммуноглобулины нейтрализуют токсины при ботулизме и столбняке.
- Антибиотики, к которым чувствительны клостридии — макролиды «Азитромицин», «Кларитромицин», цефалоспорины «Цефтриаксон», «Цефазолин», защищенные пенициллины «Амоксиклав», «Метронидазол», «Ванкомицин».
- Пробиотики и пребиотики для нормализации биоценоза кишечника – «Аципол», «Бифиформ», «Лактофильтрум», «Хилак-форте», «Линекс», «Энтерол».
- Инфузионная терапия для нормализации баланса жидкости в организме. Для борьбы с интоксикацией внутривенно вливают «Реополиглюкин».
- В тяжелых случаях применяют антигистаминные препараты и кортикостероиды.
- Симптоматическая терапия — гепатопротекторы, ферменты, энтеросорбенты, витамины, жаропонижающие средства, ноотропы, сердечные гликозиды.
Профилактика
Профилактические мероприятия, позволяющие предупредить развитие клостридиозов:
- Cоблюдение санитарных правил и норм,
- Тщательное мытье и термическая обработка продуктов питания,
- Поддержание здоровой микрофлоры кишечника и работы иммунитета,
- Своевременное выявление и изоляция инфицированных лиц,
- Определение бактерионосителей клостридии,
- Прием антибактериальных средств только по назначению врача,
- Обеспечение санитарно-гигиенического режима в ЛПУ.
В настоящее время разработана и активно применяется специфическая профилактика столбняка, которая заключается в создания активного иммунитета всем детям, начиная с 3-месячного возраста. Для иммунизации используют вакцину АКДС, АДС или АС. Проводят вакцинацию в соответствии с Национальным календарем прививок.

Антитоксические сыворотки и иммуноглобулины нейтрализуют токсины при ботулизме и столбняке.